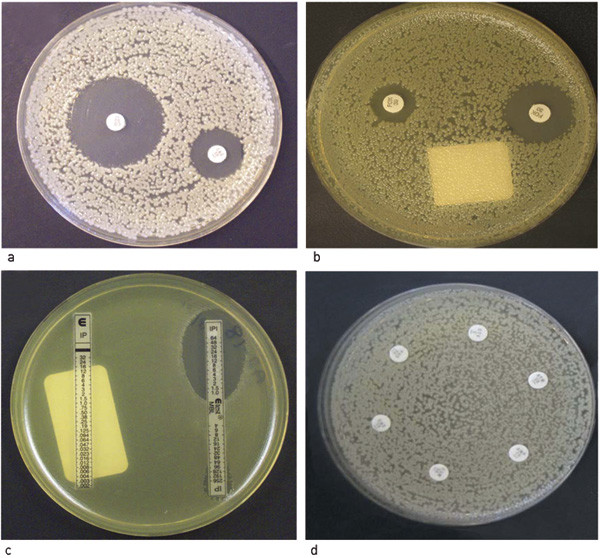
Figur 3  a) P&aring;visning av ekstendert spektrum-betalaktamaseproduserende Escherichia coli der veksthemningssonen for&hellip;

Bredspektrede betalaktamaser hos gramnegative stavbakterier
Background.
β-lactams are our most valuable and frequently used antibiotics. Resistance towards them, in both Gram-positive and Gram-negative bacteria, challenges their antimicrobial effect. β-lactamases are the most important resistance mechanism against β-lactams in Gram-negative bacteria.
Material and methods.
This review is based on literature retrieved through a non-systematic search of Pubmed (with the terms «ESBL», «AmpC», and «carbapenemases»), as well as the authors’ own research experience.
Results and interpretation.
We now observe a global dissemination of particularly broad spectrum β-lactamases; extended-spectrum β-lactamases (ESBLs), plasmid-mediated AmpC, and carbapenemases. These β-lactamases are hosted by multidrug-resistant clones of Enterobacteriaceae, Pseudomonas aeruginosa and Acinetobacter baumannii with few, if any, therapeutic alternatives. We have observed that this pandemic has reached Norway with an increase in ESBL-producing Escherichia coli in particular, but also pan-resistant carbapenemase-producing K. pneumoniae, P. aeruginosa og A. baumannii during the last years. The latter ones have been associated with import after hospitalization abroad, but this situation may change due to the epidemic potential of these resistant clones. Rapid diagnostic service and targeted infection control measures are important to prevent them from spreading.
Betalaktamantibiotika omfatter en rekke antibiotika fra førstegenerasjons smalspektrede benzylpenicilliner, via kefalosporiner og monobaktamer til bredspektrede karbapenemer (tab 1). De har et bredt indikasjonsområde på grunn av ulike antibakterielle spektre, lav toksisitet og allsidige administrasjonsformer. Betalaktamer utgjorde 45 % av det totale antibiotikaforbruket hos mennesker i Norge i 2006 (1).
Tabell 1
De vanligste grupper betalaktamantibiotika, deres antibakterielle spektrum og hvilke betalaktamaser som inaktiverer gruppen
| Betalaktamgruppe | Generiske preparater | Antibakterielt spektrum | Inaktiveres av følgende betalaktamaser |
| Smalspektrede penicilliner | Penicillin GPenicillin V | Grampositive bakterier | Penicillinaser, ESBL¹, AmpC og karbapenemaser |
| Bredspektrede penicilliner | AmpicillinAmoksicillinPiperacillin | Grampositiv + begrenset gram-negativt repertoar | Penicillinaser, ESBL¹, AmpC og karbapenemaser |
| Førstegenerasjons kefalosporiner | CefalotinCefaleksin | Grampositiv + begrenset gram-negativt repertoar | AmpC, ESBL¹ og karbapenemaser |
| Annengenerasjons kefalosporiner | CefuroksimCefoksitin | Grampositiv + utvidet gramnegativt repertoar | AmpC, ESBL¹ og karbapenemaser |
| Tredjegenerasjons kefalosporiner | CefotaksimCeftazidimCeftriakson | Bredspektret gram-positiv (unntak ceftazidim) og negativ antimikrobiell aktivitet | AmpC, ESBL¹ og karbapenemaser |
| Fjerdegenerasjons kefalosporiner | CefepimCefpirom | Bredspektret gram-positiv og negativ antimikrobiell aktivitet | ESBL¹ og karbapenemaser |
| Monobaktamer | Aztreonam | Virker kun på gramnegative bakterier | AmpC, ESBL¹ og karbapenemaser |
| Karbapenemer | ImipenemMeropenemErtapenem | Bredspektret gram-positiv og negativ antimikrobiell aktivitet | Karbapenemaser |
| [i] | |||
[i] ¹ ESBL = ekstendert spektrum-betalaktamaser
Gramnegative stavbakterier kan få overført gener som koder for enzymer (bredspektrede betalaktamaser) som inaktiverer alle eller de fleste betalaktamer (2) – (5). Spredningen av slike enzymer blant Escherichia coli, Klebsiella pneumoniae, Acinetobacter baumannii og Pseudomonas aeruginosa har pandemiske trekk. Genene som koder for særlig bredspektrede betalaktamaser er også vanligvis koblet til resistensgener mot andre klinisk viktige antibiotika i genetiske kassettsystemer (transposoner og integroner). Disse genstrukturene kan effektivt overføres mellom ulike bakterier via plasmider og medføre smittsom multiresistens (fig 1). Det er i dag beskrevet multiresistente kliniske bakterieisolater der man står uten gode behandlingsalternativer. Man har i slike situasjoner tatt i bruk colistin, et gammelt peptidantibiotikum med alvorlige bivirkninger og en problematisk farmakokinetikk (6). Slike multiresistente kliniske gramnegative isolater har også vært observert i Norge (7) – (9).

I denne artikkelen vil vi redegjøre for de senere års utvikling av overførbare bredspektrede betalaktamaser hos gramnegative stavbakterier og spesielt omtale de klinisk viktige gruppene av betalaktamaser: ekstendert spektrum-betalaktamaser, AmpC og karbapenemaser. Diagnostiske og sykehushygieniske konsekvenser diskuteres.
Metoder
Artikkelen er basert på et utvalg av litteratur etter ikke-systematisk søk i PubMed samt forfatternes forskningserfaringer.
Nye betalaktamantibiotika
Utviklingen av betalaktamantibiotika er historien om en konkurranse mellom forskning og farmasøytisk industri på den ene side og bakterienes utvikling av resistensmekanismer på den andre. Betalaktamaser hydrolyserer betalaktamringen som er en forutsetning for antibakteriell effekt (fig 2). Betalaktamringen kunne beskyttes mot de første generasjoner betalaktamaser gjennom utvikling av nye betalaktamer, og tidlig i 1960-årene ble bredspektrede penicilliner (ampicillin og karbenicillin) introdusert. Den første plasmidmedierte bredspektrede betalaktamasen (TEM-1) ble imidlertid beskrevet allerede i 1965 i et E coli-blodkulturisolat fra en gresk pasient ved navn Temoniera, derfor betegnelsen TEM (10). TEM-1 kan i dag påvises hos 30 – 60 % av kliniske E coli-isolater over hele verden (11). Den har i tillegg etablert seg i flere andre bakteriearter.

Ved introduksjonen av bredspektrede kefalosporiner (cefotaksim, ceftriakson, ceftazidim) og karbapenemer (imipenem, meropenem) i 1970- og 80-årene så man en tilsvarende utvikling. De første tilfellene av ervervede ekstenderte spektrum-betalaktamaser (ESBL) og karbapenemaser i kliniske isolater ble beskrevet kort tid etter at midlene ble tatt i bruk (11). På denne måten har fagfeltet forutsigbart bølget frem og tilbake der nye generasjoner betalaktamantibiotika har selektert frem nye betalaktamaser med stadig bredere substratprofil.
Det er i dag beskrevet flere hundre ulike betalaktamaser (12, 13) og noen av disse er i stand til å inaktivere alle typer betalaktamantibiotika. De aller fleste variantene er funnet i gramnegative stavbakterier (5, 10, 14). Bruk av betalaktamer har over tid selektert frem betalaktamaser og bakterier som hyperproduserer sin kromosomale betalaktamase, har ervervet plasmidmedierte betalaktamaser og/eller har muterte betalaktamaser med utvidet substratspektrum. Det er biologiske årsaker til at overførbare betalaktamaser og diversifiseringen av dem særlig ses hos gramnegative bakterier. Betalaktamaser hos grampositive bakterier påvises hovedsakelig ekstracellulært og beskytter dermed hele bakteriepopulasjonen. Dette gir ingen individuelle fordeler for den enkelte bakteriecelle. Hos gramnegative bakterier vil betalaktamaser hovedsakelig finnes i det periplasmatiske rom. På denne måten beskytter betalaktamasen enkeltceller fremfor hele populasjonen. Hvis det oppstår mutasjoner som medfører økt produksjon eller en ny og forbedret variant av betalaktamasen, vil derfor den individuelle bakteriecellen få en fordel som den kan selekteres for. Betalaktamaser har også en rolle i celleveggsmetabolismen, og en negativ seleksjon av ulike betalaktamaser i grampositive bakterier kan ikke utelukkes (11).
Ekstendert spektrum-betalaktamaser
Ekstendert spektrum-betalaktamaser er enzymer som har utvidet evne til å hydrolysere betalaktamer fra penicilliner og første- og annengenerasjons kefalosporiner til også å omfatte ekstendert spektrum-kefalosporiner. Disse enzymene hemmes per definisjon av tradisjonelle betalaktamaseinhibitorer (klavulansyre, tazobactam og sulbactam). Egenskapene inngår i den operasjonelle definisjonen og diagnostikken av Enterobacteriaceae, spesielt K pneumoniae og E coli (fig 3a). Enterobacteriaceae utgjorde 43 % av registrerte bakteriemiisolater i Norge i 2006 (1).
Ekstendert spektrum-betalaktamaser ble første gang beskrevet i 1980-årene (10). De første av disse enzymene var mutanter av allerede eksisterende bredspektrede betalaktamaser (TEM-1, TEM-2 og SHV-1). De ble derfor opprinnelig kalt ekstendert bredspektrum-betalaktamaser. Mutasjonene i TEM og betalaktamasen SHV medførte endringer i enzymstrukturen, slik at de effektivt kunne inaktivere nye ekstendert spektrum-kefalosporiner samtidig som de beholdt evnen til å hydrolysere de gamle. De fikk derfor en seleksjonsfordel ved bruk av nye kefalosporiner som ble svært populære i 1980-årene. Stadig nye varianter av disse betalaktamasene er blitt beskrevet, og de var inntil for få år siden de dominerende ekstendert spektrum-betalaktamaser-typene over hele verden. Det er i dag beskrevet over 100 SHV- og 150 TEM-varianter (12).
De siste årene har det skjedd en interessant endring i epidemiologien til ekstendert spektrum-betalaktamaser (3, 14). Den såkalte CTX-M (cefotaksimase-München) er nå den dominerende typen globalt, inkludert i Skandinavia (15) – (17). Det er økende forekomst av CTX-M-produserende E coli både innenfor og utenfor sykehus (18, 19). Slike stammer er ofte multiresistente, og man står igjen med få effektive behandlingsalternativer. Infeksjonspanoramaet domineres av urinveisinfeksjoner, men også en økende andel systemiske E coli-isolater rapporteres som ekstendert spektrum-betalaktamase-produserende. Det er rapportert vellykket behandling med mecillinam av enkelttilfeller av urinsveisinfeksjoner forårsaket av ekstendert spektrum-betalaktamase-produserende E coli (20). Ekstendert spektrum-betalaktamaseenzymer kan imidlertid ha svært ulike substratprofiler, og det er derfor nødvendig med større studier for å trekke noen generelle konklusjoner om effekten av mecillinam ved urinveisinfeksjoner forårsaket av ESBL-produserende Enterobacteriaceae.
Vi gjennomførte en nasjonal studie av denne typen Enterobacteriaceae i 2003 – 05 i samarbeid med norske mikrobiologiske laboratorier (15). Resultatene viste at Norge tok del i den globale spredningen av multiresistente CTX-M-produserende E coli. I 2004 ble det registrert et klonalt utbrudd av slike bakterier ved et norsk sykehus (21). Klinisk vurdering av de åtte berørte pasientene viste at infeksjonen hadde bidratt til for tidlig død hos tre pasienter, sannsynligvis på grunn av forsinket effektiv antibiotikaterapi. En større epidemi av CTX-M-produserende K pneumoniae har pågått ved Akademiska sjukhuset i Uppsala siden 2005 (22). Dette illustrerer behovet for aktsomhet for epidemiske problemer også i vår del av verden.
Bakteriemier med ekstendert spektrum-betalaktamaseproduserende Enterobacteriaceae er assosiert med økt sykelighet og dødelighet, forlenget sykehusopphold og økte kostnader (23). Internasjonale molekylære studier av CTX-M-produserende E coli viser genetisk nært beslektede bakterievarianter (kloner) som har stor evne til spredning og kolonisering innenfor og utenfor sykehus (24). Videre vet vi at pasienter med infeksjoner forårsaket av denne bakterietypen og deres husstandsmedlemmer ofte er kolonisert med de samme bakteriestammene i sin tarmflora (25, 26). Påvisning av ekstendert spektrum-betalaktamaseproduserende Enterobacteriaceae vil derfor medføre klassiske smitteverntiltak under institusjonsopphold (26). Det er også nødvendig å begrense bruken av selekterende og ineffektiv antimikrobiell terapi. Siden tarmkolonisering er en anerkjent risikofaktor for urinveisinfeksjoner og bakteriemier forårsaket av CTX-M-produserende E coli vil konsentrasjonen av antibiotika i tarm sannsynligvis være særlig viktig. Bruk av parenterale aminoglykosider gir sjelden tarmkonsentrasjoner av selektiv betydning, og det kan derfor være fordelaktig å bruke slik behandling sett i lys av lokale resistensforhold (26). Vi har mangelfulle kunnskaper om varigheten og omfanget av bærerskap av ekstendert spektrum-betalaktamase, smittefaren det representerer og eventuell oppfølging av den enkelte bærer. Man bør derfor være tilbakeholden med å innføre individrettede restriksjoner på grunn av bærerskap av nye, om enn klinisk viktige, antibiotikaresistente bakterier.
AmpC-betalaktamaser
De fleste Enterobacteriaceae utenom Klebsiella og Salmonella har iboende kromosomale AmpC-betalaktamaser. Uttrykket av disse genene er nøye regulert, men hyperproduserende mutanter kan selekteres frem under behandling med nyere ekstendert spektrum-kefalosporiner (4). Man anbefaler derfor ikke bruk av tredjegenerasjons kefalosporiner som monoterapi ved systemiske infeksjoner forårsaket av Enterobacter spp., Serratia spp., Citrobacter freundii eller Morganella morganii. AmpC-hyperproduserende mutanter uttrykker resistens mot alle betalaktamer med unntak av karbapenemer og fjerdegenerasjons kefalosporiner (cefepim, cefpirom). I motsetning til ekstendert spektrum-betalaktamaser medierer AmpC også resistens mot cefamyciner (cefoksitin), og AmpC-enzymer hemmes ikke av klavulansyre eller andre tradisjonelle betalaktamaseinhibitorer. I diagnostisk sammenheng benytter man seg av at AmpC hemmes av borsyre og kloksacillin (27, 28) (fig 3b).
Mange ulike kromosomale ampC-gener er blitt mobilisert og overført til plasmider (29). Plasmidmedierte ampC er unndratt normal regulering av genuttrykk, og man finner derfor hyperproduksjon av AmpC-enzymene. Fenotypisk vil plasmidmediert AmpC vanligvis ikke kunne skilles fra hyperproduksjon av kromosomal AmpC (27, 28). Dette er særlig et diagnostisk problem hos E coli. Plasmidmedierte ampC vil imidlertid ofte være koblet til andre resistensgener på samme plasmid, og bakteriestammen kan derfor forventes å være resistente mot andre klinisk viktige antibiotika. Undersøkelse av et nasjonalt E coli-materiale innsamlet ved Kompetansesenteret for påvisning av antibiotikaresistens (K-Res) 2003 – 07 viste at multiresistens kombinert med høye MIC-verdier mot ekstendert spektrum-kefalosporiner var assosiert med plasmidmediert AmpC fremfor hyperproduksjon av den kromosomale AmpC (30).
Det har sykehushygienisk betydning å skille mellom kromosomal og plasmidmediert AmpC-hyperproduksjon hos E coli. Det har vært beskrevet flere utbrudd forårsaket av Enterobacteriaceae med plasmidmediert AmpC (31). Det må derfor antas at slike stammer har et epidemisk spredningspotensial på linje med ekstendert spektrum-betalaktamaseproduserende Enterobacteriaceae og bør utløse tilsvarende smitteverntiltak.
Karbapenemaser
Overførbare karbapenemaser har de siste årene fått stor oppmerksomhet internasjonalt. Dette skyldes epidemiske trekk ved utviklingen og terapeutiske konsekvenser. Mange karbapenemaser inaktiverer alle betalaktamgrupper. Karbapenemasegenene finnes ofte på mobile genetiske elementer sammen med resistensgener mot andre klinisk viktige antibiotika (2, 5). Ved påvisning av klinisk relevante karbapenemaseproduserende bakterier må man derfor sette i verk klassiske smitteverntiltak som beskrevet for andre særlig bredspektrede betalaktamaser (26). Vi omtaler her de tre vanligst forekommende gruppene av overførbare karbapenemaser: metallobetalaktamaser (MBL), oxacillinaser (OXA), og Klebsiella pneumoniae-karbapenemase (KPC)
Metallobetalaktamaseenzymer nøytraliserer alle betalaktamer unntatt monobaktamer (aztreonam). Den første overførbare metallobetalaktamasen (imipenemasen, IMP-1) ble beskrevet i 1991 hos et klinisk P aeruginosa-isolat (32). Siden er det påvist flere typer: VIM, GIM, SPM og SIM (2, 5). Enzymene benevnes metallobetalaktamaser fordi de er avhengige av sinkioner. Dette utnyttes diagnostisk ved at metallobetalaktamaseaktivitet kan hemmes med tilsetning av kjemiske stoffer som binder sink (fig 3c). De hemmes ikke av tradisjonelle betalaktamaseinhibitorer. Overførbare metallobetalaktamaser har størst utbredelse i P aeruginosa, som er iboende resistent mot en rekke andre antimikrobielle midler. Genene som koder for metallobetalaktamaser er vanligvis lokalisert på integroner sammen med andre resistensgener, og ervervelse av metallobetalaktamaser gjør derfor P aeruginosa resistent mot nesten alle aktuelle antimikrobielle midler. I mange tilfeller er de kun følsomme in vitro for colistin alene eller i eksperimentelle kombinasjoner med andre antibiotika (6). Slike stammer ble påvist blant de første norske kliniske metallobetalaktamaseproduserende P aeruginosa-isolatene (7) – (9).
De senere år har mobile metallobetalaktamaser i økende grad blitt funnet i vanlig forekommende gramnegative stavbakterier som E coli og K pneumoniae (2, 33). De første norske tilfellene av metallobetalaktamaseproduserende K pneumoniae ble påvist i 2007 (9). Erfaringer fra sykehus i Hellas med endemisk forekomst av karbapenemresistente K penumoniae tilsier et epidemisk spredningspotensial. Fenotypisk påvisning av produksjon i Enterobacteriaceae kan være utfordrende fordi de ofte uttrykker lavgradig karbapenemresistens i laboratoriet. Nedsatt følsomhet for karbapenemer hos Enterobacteriaceae er svært sjelden og derfor en indikasjon for videre undersøkelse ved referanselaboratorium.
Oxacillinaser er en stor og heterogen gruppe betalaktamaser der noen medierer karbapenemaseaktivitet som inaktiverer alle klinisk viktige betalaktamer (4, 5). Som klinisk problem er disse oftest assosiert med kliniske isolater av A baumannii (34). A baumannii har en rekke iboende resistensmekanismer, inkludert kromosomale gener (OXA-51/69) som koder for oxacillinaser med karbapenemaseaktivitet. OXA-51/69-genene er normalt lavgradig uttrykt, men genetiske endringer kan føre til hyperproduksjon. I tillegg er A baumannii notorisk kjent for lett å erverve resistens gjennom genetiske endringer (fig 3d). Påvisningen av et mobilt genetisk element med 45 ulike resistensgener i en fransk epidemisk A baumannii-klon illustrerer dette fenomenet (35). Molekylære epidemiologiske studier av karbapenemresistente A baumannii i Europa har vist epidemiske kloner med ervervede oxacillinasekarbapenemaser og økt potensial for spredning og kolonisering (36). Det var kanskje en slik stamme som forårsaket infeksjonsutbruddet blant fire pasienter ved Brannskadeavdelingen på Haukeland Universitetssykehus i slutten av 1990-årene (37). Foreløpig er det ingen gode fenotypiske metoder for påvisning av oxacillinasekarbapenemaser. Kompetansesenteret for påvisning av antibiotikaresistens (K-Res) har et pågående forskningsprosjekt for karakterisering av multiresistente A baumannii og tar imot slike stammer for nærmere undersøkelse.
K pneumoniae-karbapenemaser (KPC) ble første gang beskrevet i 2001 i et klinisk K pneumoniae-isolat fra USA (38). De er plasmidmedierte og er senere også blitt påvist i andre Enterobacteriaceae og i P aeruginosa (5). KPC-produserende K pneumoniae ble initialt observert i USA, men har de senere år også forårsaket større utbrudd på sykehus i Israel og Hellas (5, 32, 39). Karbapenemresistens ble rapportert hos 32 % av K pneumoniae-blodkulturisolater fra Hellas i 2006 og synes assosiert med høy forekomst av både VIM-MBL og KPC (32, 39). I Norge er det nylig bekreftet tre tilfeller av KPC-produserende K pneumoniae. Minst ett av isolatene ble sannsynligvis ervervet i forbindelse med sykehusopphold i Hellas (Kompetansesenteret for påvisning av antibiotikaresistens, upubliserte data). Slike stammer er ikke uventet multiresistente. Resistensbestemmelse av de norske isolatene viste kun følsomhet for henholdsvis ett og to antimikrobielle midler. Mistanke om K pneumoniae-karbapenemaseproduserende Enterobacteriaceae forsterkes ved nedsatt følsomhet for karbapenemer kombinert med multiresistens. Endelig verifisering utføres ved referanselaboratorium. For oppdatert informasjon om mikrobiologisk diagnostikk av særlig bredspektrede betalaktamaser henvises til hjemmesiden til Arbeidsgruppen for antibiotikaspørsmål og Kompetansesenteret for påvisning av antibiotikaresistens som i samarbeid har et nasjonalt fagansvar på dette området (40).
Avslutning
Antibiotikaresistens forstås som en konkurranse mellom bakterienes plastisitet og utviklingen av nye antimikrobielle midler. En særlig utfordring de nærmeste årene synes å være knyttet til gramnegative stavbakterier der vi dag ikke kan forvente nye effektive antimikrobielle midler mot multiresistente stammer. Den globale økningen i forekomst av bakterier med overførbare resistensenzymer med genetisk koblet multiresistens er derfor bekymringsfull. Utviklingen ser videre ut til å være assosiert med spesifikke kloner av E coli, K pneumoniae, A baumannii og P aeruginosa, med økt potensial for spredning og kolonisering. Det er viktig at norske helsearbeidere er oppmerksomme på denne utviklingen. Til nå har slike bakteriestammer hovedsaklig vært et importfenomen i Norge, men historien har vist at dette kan endre seg. Riktig antibiotikabruk, rask mikrobiologisk diagnostikk og målrettede smitteverntiltak vil være avgjørende for å begrense resistensproblemene på norske helseinstitusjoner.
Oppgitte interessekonflikter:
Ingen
Tabell
| Hovedbudskap |
|
- 1.
NORM/NORM-VET 2006. Usage of antimicrobial agents and occurrence of antimicrobial resistance in Norway. www.vetinst.no/nor/Forskning/Rapporter/Norm-Norm-Vet-rapporten (28.8.2008).
- 2.
Walsh TR, Toleman MA, Poirel L et al. Metallobetalactamases: the quiet before the storm? Clin Microbiol Rev 2005; 18: 306 – 25.
- 3.
Canton R, Coque TM. The CTX-M betalactamase pandemic. Curr Opin Microbiol 2006; 9: 466 – 75.
- 4.
Livermore D, Woodford N. The beta-lactamase threat in Enterobacteriaceae, Pseudomonas and Acinetobacter. Trends Microbiol 2006; 14: 2974 – 6.
- 5.
Queenan Am, Bush K. Carbapenemases: the versatile beta-lactamases. Clin Microbiol Rev 2007; 20: 440 – 58.
- 6.
Zavascki AP, Goldani LZ, Nation RL. Polymyxin B for the treatment of multidrug-resistant pathogens: a critical review. J Antimicrob Chemother 2007; 60: 1206 – 15.
- 7.
Samuelsen Ø, Buarø L, Giske CG et al. Evaluation of phenotypic tests for the detection of metallo-beta-lactamase-producing Pseudomonas aeruginosa in a low prevalence country. J Antimicrob Chemother 2008: 61: 827 – 30.
- 8.
Samuelsen Ø, Toleman MA, Hermansen NO et al. The first metallo-beta-lactamse producing clinical isolate of Pseudomonas aeruginosa in Norway. Abstract 17th European Congress of Clinical Microbiology and Infectious Diseases. München: ECCMID, 2007.
- 9.
Samuelsen Ø, Buarø L, Aasnæs B et al. The emergence of metallo-beta-lactamase producing P. aeruginosa and Klebsiella pneumoniae in Scandinavia. Abstract 18th European Congress of Clinical Microbiology and Infectious Diseases. Barcelona: ECCMID, 2008.
- 10.
Bradford PA. Extended-spectrum beta-lactamases in the 21st century: characterization, epidemiology, and detection of this important resistance threat. Clin Microbiol Rev 2001; 14: 933 – 51.
- 11.
Livermore D. Beta-lactamase mediated resistance and opportunities for its control. J Antimicrobial Chemother 1998; 41 (suppl D): 25 – 41.
- 12.
Lahey clinic. www.lahey.org/studies (28.8.2008).
- 13.
OXY,OKP, LEN beta-lactamase protein variation home page. www.pasteur.fr/recherche/genopole/PF8/betalact_en.html (28.8.2008).
- 14.
Livermore D. Defining an extended-spectrum betalactamase. Clin Microbiol Infect 2008; 14 (suppl 1): 3 – 10.
- 15.
Tofteland S, Haldorsen B, Dahl KH et al. Effects of phenotype and genotype on methods for detection of extended-spectrum-beta-lactamase-producing clinical isolates of Escherichia coli and Klebsiella pneumoniae in Norway. J Clin Microbiol 2007; 45: 199 – 205.
- 16.
Nyberg SD, Osterblad M, Hakanen J et al. Detection and molecular genetics of extended-spectrum beta-lactamases among cefuroxime-resistant Escherichia coli and Klebsiella spp. isolates from Finland, 2002 – 2004. Scand J Infect Dis 2007; 39: 417 – 24.
- 17.
Fang H, Ataker F, Hedin G et al. Molecular epidemiology of extended-spectrum beta-lactamases among Escherichia coli isolates collected in a Swedish Hospital and its associated health care facilities from 2001 to 2006. J Clin Microbiol 2008; 46: 707 – 12.
- 18.
Oteo J, Navarro C, Cercenado E et al. Spread of Escherichia coli strains with high-level cefotaxime and ceftazidime resistance between the community, long-term care facilities, and hospital institutions. J Clin Microbiol 2006; 44: 2359 – 66.
- 19.
Livermore DM, Canton R, Gniadkowski M et al. CTX-M: changing the face of ESBLs in Europe. J Antimicrob Chemother 2007; 59: 165 – 74.
- 20.
Nicolle LE, Mulvey MR. Successful treatment of CTX-M ESBL producing Escherichia coli relapsing pyelonephritis with long term pivmecillinam. Scand J Infect Dis 2007; 39: 748 – 9.
- 21.
Naseer U, Natås OB, Haldorsen BC et al. Nosocomial outbreak of CTX-M-15-producing E. coli in Norway. APMIS 2007; 115: 120 – 6.
- 22.
Søderholm T, Struwe J. Extended spectrum beta-lactamase-producing Enterobacteriaceae: the first six months of notifications according to the Swedish communicable disease act. Eurosurveillance 2007; 12: E071018.1
- 23.
Schwaber MJ, Navon-Venezia S, Kaye KS et al. Clinical and economic impact of bacteremia with extended- spectrum-beta-lactamase-producing Enterobacteriaceae. Antimicrob Agents Chemother 2006; 50: 1257 – 62.
- 24.
Coque TM, Novaia A, Carattoli A et al. Dissemination of clonally related Escherichia coli strains expressing extended-spectrum beta-lactamase CTX-M-15. Emerg Infect Dis 2008; 14: 195 – 200.
- 25.
Valverde A, Coque TM, Sanchez-Moreno MP et al. Dramatic increase in prevalence of fecal carriage of extended-spectrum beta-lactamase-producing Enterobacteriaceae during nonoutbreak situations in Spain. J Clin Microbiol 2004; 42: 4769 – 75.
- 26.
Warren RE, Harvey G, Carr R et al. Control of infections due to extended-spectrum beta-lactamase-producing organisms in hospitals and the community. Clin Microbiol Infect 2008; 14 (suppl 1): 124 – 33.
- 27.
Jacoby GA, Walsh KE, Walker VJ. Identification of extended-spectrum, AmpC, and carbapenem- hydrolyzing beta-lactamases in Escherichia coli and Klebsiella pneumoniae by disk tests. J Clin Microbiol 2006; 44: 1971 – 6.
- 28.
Giske CG, Haldorsen B, Lundblad EW et al. Phenotypic detection of AmpC: Comparison of Etest AmpC strips and disk synergy assays with cloxacillin, boronic acid and EDTA. Abstract 17th European Congress of Clinical Microbiology and Infectious Diseases. München: ECCMID, 2007.
- 29.
Philippon A, Arlet G, Jacoby GA. Plasmid-determined AmpC-type beta-lactamases. Antimicrob Agents Chemother 2002; 46: 1 – 11.
- 30.
Haldorsen B, Aasnæs B, Dahl KH et al. the AmpC phenotype in Norwegian clinical isolates of Escherichia coli is associated with an acquired ISEcp1-like ampC element or hyperproduction of the endogenous AmpC. J Antimicrob Chemother 2008; 62: 694 – 702.
- 31.
Li Y, Li Q, Du Y et al. Prevalence of plasmid-mediated AmpC beta-lactamasese in a Chinese University Hospital from 2003 to 2005: first report of CMY-2 AmpC beta-lactamase resistance in China. J Clin Microbiol 2008; 46: 1317 – 21.
- 32.
Watanabe M, Iyobe S, Inoue M et al. Transferable imipenem resistance in Pseudomonas aeruginosa. Antimicrob Agents Chemother 1991; 35: 147 – 51.
- 33.
The European Antimicrobial Resistance Surveillance System. EARSS annual report 2006. www.rivm.nl/earss (28.8.2008).
- 34.
Perez F, Hujer AM, Hujer KM et al. Global challenge of multidrug-resistant Acinetobacter baumannii. Antimicrob Agents Chemother 2007; 51: 3471 – 84.
- 35.
Fournier PE, Vallenet D, Barbe V et al. Comparative genomics of multidrug resistance in Acinetobacter baumannii. PLoS Genet 2006; 2: e7.
- 36.
Coelho JM, Turton JF, Kaufmann ME et al. Occurrence of carbapenem-resistant Acinetobacter baumannii clones at multiple hospitals in London and Southeast England. J Clin Microbiol 2006; 44: 3623 – 7.
- 37.
Onarheim H, Høivik T, Harthug S et al. Utbrudd av multiresistent Acinetobacter baumannii infeksjon Tidsskr Nor Lægeforen 2000; 120: 1028 – 33.
- 38.
Yigit H, Queenan AM, Anderson GJ et al. Novel carbapenem-hydrolyzing beta-lactamase, KPC-1, from a carbapenem-resistant strain of Klebsiella pneumoniae. Antimicrob Agents Chemother 2001; 45: 1151 – 61.
- 39.
Vourli S, Giakkoupi P, Polemis MZ et al. Study of the molecular epidemiology of metallo-beta-lactamase-producing Klebsiella pneumoniae in Greece. Abstract 18th European Congress of Clinical Microbiology and Infectious Diseases. Barcelona: ECCMID, 2008.
- 40.
Universitetssykehuset Nord-Norge. Antibiotika og antibiotikaresistens. www.antibiotikaresistens.no (28.8.2008).